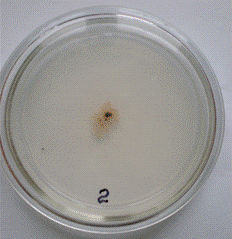

Индукция системной устойчивости у растений пшеницы к Mycosphaerella graminicola
Введение
Сумчатый фитопатогенный гриб Mycosphaerella graminicola (Fuckel)
J. Schrцt. in Cohn (известный также по названию анаморфы Septoria tritici Roberge
in Desmaz.) является возбудителем септориозной пятнистости листьев пшеницы (septoria
leaf blotch of wheat.). Он повсеместно распространен и представляет собой
вредоносного возбудителя заболевания озимой и яровой пшеницы, особенно в зонах
с влажным умеренным климатом. В Украине септориоз наиболее часто встречается в
лесостепной зоне и Полесье. При эпифитотиях потери урожая, вызываемые M.
graminicola, могут достигать 30-40%. Кроме снижения урожая зерна, септориоз
также вызывает понижение его качества [12; 14; 16].
Патоген и вызываемое им заболевание были изучены достаточно
детально в XIX и первой половине XX века. Однако после внедрения в производство
карликовых высокоурожайных восприимчивых сортов пшеницы, применения высоких доз
азотных удобрений и других приемов интенсивной агротехники возделывания
пшеницы, M. graminicola начала рассматриваться как опасный патоген,
который может в значительной степени снижать потенциальную продуктивность
пшеницы [53].
Стратегия контроля септориоза пшеницы в настоящее время
основана на применении фунгицидов. Однако изоляты M. graminicola довольно
быстро приобретают устойчивость к фунгицидам, в том числе и самым новейшим,
включая стробилурины и другие группы. Таким образом, поиск новых эффективных
препаратов для контроля септориоза является актуальной задачей [50].
Одной из самых новых групп фунгицидов являются индукторы
системной устойчивости растений. В настоящее время имеются коммерческие
препараты этой группы - функциональные аналоги салициловой кислоты. Однако
спектры индукции системной устойчивости различаются у разных растений. В связи
с этим важным вопросом является возможность индукции системной приобретенной
устойчивости у растений пшеницы по отношению к возбудителю септориоза. До
настоящего момента в научной литературе сведения отсутствуют. Существует
единственная публикация русских авторов по данной тематике, однако системную
устойчивость пшеницы индуцировали к S. nodorum [8; 33; 46; 50;].
В связи со сказанным целью настоящей работы было изучение
возможности индукции системной приобретенной устойчивости у пшеницы по
отношению к M. graminicola.
Для достижения поставленной цели предусматривалось решение
таких задач:
1. Выделить изоляты M. graminicola в чистую культуру.
2. Отработать методы заражения растений пшеницы.
. Индуцировать системную приобретенную устойчивость у
пшеницы посредством ее обработки салициловой кислотой.
1.
Обзор литературы
.1
Таксономия
graminicola (анаморфа Septoria tritici)
относится к царству Fungi, отделу Ascomycota, подотделу Pezizomycotina, классу
Dothideomycetes, подклассу Dothideomycetidae, порядку Capnodiales, семейству Mycosphaerellaceae.
В соответствии с базой данных Species Fungorum, синонимами являются Septoria
curtisiana Sacc., S. graminum Desm., S. tritici Berk. & M.A.
Curtis, S. tritici var. lolicola R. Sprague & Aar.G. Johnson, Sphaerella
graminicola Fuckel [13; 18; 49; 53].
1.2
Биологические особенности
септориозный пшеница устойчивость системный
В естественных условиях на пораженных растениях M
graminicola формирует два типа плодоношения: бесполое, представленное
пикнидами, и половое плодоношение в виде псевдотециев [7; 29].
Пикниды шаровидные или шаровидно-эллиптические, рассеяны
группами или расположены рядами вдоль жилок на обеих поверхностях листьев,
погруженные под эпидермисом в подустьечных камерах, диаметром 75-270 мкм, с
округлым или овальным устьицем, 30-40 Ч 15-18 мкм диаметром, с оболочкой из
плектенхиматической ткани, состоящей из 2-3 слоев крупных клеток,
светло-коричневые, бурые или желтые. Пикноспоры цилиндрические, прямые или
слегка согнутые, зеленоватые или почти бесцветные, некоторые со многими каплями
жира, с закругленными или тупозакругленными концами, выходят каплями мясного
цвета, с 3-4, реже 5-7 перегородками, 36-98 Ч 2-3,5-5 мкм [7; 28].
Помимо пикнид, на пораженных частях растений были обнаружены
микропикниды диаметром 30-75 мкм, которые содержали бесцветные слабо
искривленные споры размером 8-10,5 Ч 0,8-1 мкм. Споры из микропикнид не
прорастали ни на питательных средах, ни на поверхности листьев пшеницы.
Возможно, микропикниды могут играть роль спермациев [40].
Псевдотеции шаровидные, слегка сжатые, темно-коричневые,
имеют размер 76-80 Ч 77-100 мкм. Псевдотеции слегка погружены в мертвую
растительную ткань и имеют двухслойную стенку. Сумки битуникатные, грушевидные,
размером 34-41 Ч 11-13 мкм, содержат восемь аскоспор. Парафизы отсутствуют.
Аскоспоры двухклеточные, прозрачные, эллиптической формы, одна клетка обычно
немного крупнее, размер 10-15 Ч 2,5-3 мкм [28; 40].
Размер генома, в зависимости от изолята, оценивается в 31 -
40 млн. п.н., число хромосом варьирует от 18 - 20, и длинна хромосом составляет
от 0,3 до 6 млн. п.н. Эти данные свидетельствуют, что M. graminicola
имеет самое большое число хромосом и саме маленькие аутосомы среди формирующих
гифы аскомицетов. Интересно, что, несмотря на различия в общих размерах генома
и числе хромосом, у изолятов отсутствуют различия развития патогенности и
различия в половом размножении (это свидетельствует о том, что геном на 17-22%
избыточен) [32; 33; 50; 53].
.3
Рост в чистых культурах
Гриб относительно легко культивируется на различных питательных
средах. Морфолого-культуральные особенности зависят от изолята гриба и состава
используемой питательной среды. В общем случае, при посеве на питательную среду
пикнидиоспор или аскоспор, M graminicola начинает расти в дрожжеподобной
форме, формируя небольшие светлые колонии. Далее колонии становятся
мицелиального или смешанного (мицелиально-дрожжеподобные) типа, формируется
темная строма, в которой развиваются пикниды гриба [3; 9; 15; 40].
Однако морфология колоний гриба в сильной степени зависит как
от конкретного изолята, так и от состава питательной среды. Одной из наиболее
подходящих сред культивирования, на которой происходит типичное развитие
колоний M. graminicola, является картофельно-декстрозный или
картофельно-глюкозный агар (КГА). В то же время, например, на среде
Чапека-Докса гриб растет в виде дрожжеподобных культур, со скудным мицелием.
Помимо полноценных пикнид, гриб часто формирует подобные пикнидам структуры, не
содержащие пикноспор («псевдопикниды») [3; 9; 15; 40; 43].
Из пораженных растений достаточно часто выделяются
«атипичные» изоляты гриба. Например, моноспоровые колонии гриба, выделенные в
Аргентине из пораженных сортов с устойчивой зародышевой плазмой Bobwhite’S’ и
Kavkaz, выявляли отличия от колоний изолятов «дикого типа», характерных для
Аргентины (строматично-пикнидиальных или дрожжеподобных розовато-палевых по
цвету). Три культуральных варианта были названы мицелиально-филаментозный,
атипичный дрожжеподобный и альбиносный тип. Все атипичные варианты были
патогенными и вызывали характерные поражения, но формировали в сравнении с
изолятами дикого типа более мелкие пикниды с более мелкими пикнидиоспорами [29;
30].
.4
Патологический процесс
Симптомы
M. graminicola может заражать как проростки так и
взрослые растения. Обычно патоген заражает листья, но также может вызывать
небольшие пятнистости на колосковых чешуях. Начальными симптомами являются
желтоватые и хлоротичные пятна, чаще обнаруживаемые на нижних листьях, особенно
на тех, которые контактируют с почвой (Рис. 1). Эти пятна увеличиваются до
поражений неправильной формы, имеющие окраску от коричневой до желтовато -
коричневой. Через некоторое время, центральные части поражений белеют и
приобретают серую или пепельно-голубую окраску. В течении этого времени в
центре появляются маленькие темные пикниды, имеющие окраску от коричневой до
черной. Они формируются на верхней стороне листовой пластинки. Наиболее бурное
развитие септориоза наблюдается, начиная с фазы появления флагового листа. При
макроскопическом анализе септориозных пятен на устойчивых к заболеванию
образцах пикнид гриба не выявлено, а на стеблях растений симптомы заболевания
не проявляются. Присутствие маленьких черных пикнид в участке поражения
является наиболее надежным признаком для идентификации заболевания [9; 50].
M. graminicola не имеет узкой специализации и в
естественных условиях или при искусственном заражении вызывает заболевание, по
меньшей мере, у 15 родов дикорастущих и культурных злаков, в частности у Agropyron
spp., Agrostis spp., Brachypodium spp., Bromus spp., Dactylis
spp., Festuca spp., Hordeum spp., Glyceria spp., Poa
spp., Secale cereale и Triticum spp. Однако, по всей
видимости, не все эти растения могут служить эффективными альтернативными
хозяевами патогена в естественных условиях [24; 35; 64].

Рис. 1. Септориозная пятнистость на листьях (А) и поражение,
покрытое пикнидами патогена крупным планом (В) [14].
Влияние
внешних условий на развитие септориоза
Важнейшее влияние на динамику патологического процесса в
посевах пшеницы оказывают температура и длительность влажного периода после
заражения [64].
Латентный период заболевания (от заражения до формирования
первых пикнид) варьирует в зависимости от сортовых особенностей, влажности и
температуры и в модельных экспериментах составлял от 15 до 37 суток [55; 69].
Минимальная температура, при которой происходит развитие
патогена, составляет около 2,5° С. При изменении температуры в интервале от 11°
С до 25° С развитие заболевания усиливалось, но при росте температуры до 29° С
оно резко снижалось [42; 47; 66].
Значительный эффект оказывает также длительность периода
высокой влажности (близкой к 100%) после заражения, и развитие заболевания
усиливалось при увеличении этого периода от 24 до 96 часов. При периоде высокой
влажности менее 24 часов заболевание не проявлялось [27; 36; 42].
Освещение снижает вероятность заражения пшеницы, но
способствует развитию заболевания после внедрения патогена [56].
Обобщая, можно отметить, что заболеванию способствует
дождливая облачная погода с температурой 20-25° С [36].
Проникновение
и колонизация хозяина
После попадания на лист хозяина аскоспоры и пикнидоспоры
прорастают в условиях высокой влажности, формируя ростковые трубки и гифы
мицелия (Рис. 2). Прорастание споры начинается не ранее как через 12 часов
после контакта с листом. Пикнидоспоры M. graminicola прорастают в
свободной воде из обоих концов споры. Прорастание спор при контакте с листом
происходит независимо от устойчивости сорта [26; 29].
Противоречивые сведения приводятся относительно характера
роста гиф гриба по поверхности растений. Ряд исследователей отмечают, что гифы
растут в случайном направлении. В других случаях был отмечен ориентированный
рост ростковых трубок по направлению к устьицам, что вероятно свидетельствует о
реакции гриба на тигмотропические сигналы [33; 43].

Рис. 2. Проникновение M. graminicola через устьце [50]
Проникновение происходит почти всегда через устьица, но также
возможно и через кутикулу. При контакте с гребнями на замыкающих клетках устьиц
или иногда на антиклинальных клеточных стенках в углублениях между клетками
эпидермиса на кончиках ростковых трубок формируются структуры, напоминающие
апрессории (рис. 3), наблюдалось также прямое проникновение гиф между
замыкающими клетками устьиц, без формирования апрессориев; по этой причине Кема
с соавторами отмечают, что вероятно эти структуры не являются истинными
апрессориями и нужны не для проникновения, а возможно для прикрепления гриба,
однако другие специалисты эти структуры считают именно апрессориями. Таким
образом, роль этих структур гриба в процессе проникновения требует уточнения
[28; 33; 43].
Гифы, растущие через устьица, сжимаются
приблизительно до 1 мкм в диаметре, затем становятся более широкими после достижения
межклеточного пространства. Гриб колонизирует межклеточное пространство
мезофилла листа, не образуя питательных структур, таких как гаустории [28; 50].

Рис. 3. Дифференциация кончиков ростковых трубок над замыкающими
клетками устьиц (L) может представлять апрессории. Сканирующая электронная
микроскопия [33]
В восприимчивых культурных сортах растений
образуется большая биомасса грибных гиф тогда, как в устойчивых сортах развитие
ограничено (Рис. 3). Несмотря на присутствие большого количества грибной ткани,
видимые признаки инфекции отсутствуют на поверхности листа во время этой фазы.
Макроскопические признаки не появляются в течение приблизительно 9 дней за
исключением случайных мертвых клеток [50; 67].

Рис. 4. Распространение мицелия патогена по межклетникам
пшеницы
При оптимальных условиях 20-25оC и высокой
относительной влажности наблюдается разрушение клеток мезофилла, что приводит к
хлорозу и некрозу листа пшеницы (Рис. 4). Скорость разрушения клеток мезофилла
и тот факт, что поражаются клетки без мицелия, говорят о наличии токсических
веществах вовлеченных во взаимодействие пшеница - M. graminicola. Однако
никаких биологически активных веществ произведенных этим микроорганизмом пока
не выделено [24; 50].
Для устойчивых сортов характерно
завершение развития жизнедеятельности гриба на ранних стадиях образования
пикнид (основным защитным механизмом рассматривают лигнификацию). На
чувствительных же - при оптимальных условиях пикниды формируются спустя 14-21
день после заражения. На некоторых изолятах могут формироваться без образования
некрозов. Пикниды располагаются параллельно сосудистым пучкам, связаны с
устьицами. На протяжении периода высокой влажности, зрелые пикниды выделяют
матрикс (цирри) из остеол (отверстие раскрытой пикниды). Всего выходит 5-10 x
103 спор, 40-60% - во время первой фазы влажности (Рис. 5). Цирри
представляют собой трубкоподобное гелеобразное вещество, белково-углеводного
состава. Первичная роль - защита пикноспор от высыхания и предотвращения
преждевременного прорастания. Цирри обеспечивают жизнеспособность пикноспор по
крайней мере на 28 дней.

Рис. 5. Выход конидий [43].
Образование
половой стадии
Телеморфная стадия, первоначально
найденная в Новой Зеландии в 1972 году, в дальнейшем была обнаружена
практически везде, где встречается патоген, в частности в Канаде, Германии,
Франции, Дании, Австралии, Великобритании [37; 52] (Рис. 6).

Рис. 6. Сумки, содержащие споры [50].
Подробности формирования плодовых тел Mycosphaerella
graminicola к настоящему времени детально не описаны. Гриб является
гетероталличным, то есть для образования аскоспор необходимо взаимодействие
двух штаммов гриба с противоположными типами спаривания. Тип спаривания M.
graminicola определяется двумя различными негомологичными аллелями
(идиоморфами) в единственном локусе [43].
Псевдотеции формируются в природных условиях на пораженных
растениях, в чистых культурах половую стадию гриба получить не удается, по
крайней мере, на сегодняшний день. Плодовые тела образуются на мертвых тканях
листьев в пределах септориозных поражений, и например в условиях Великобритании
на озимой пшенице образование псевдотециев наблюдается, в зависимости от
погодных условий, в интервале от 62 до 95 дней после формирования пикнид.
Однако, при способствующих условиях в Нидерландах, M. graminicola способно
к завершению полового цикла в течение 35 дней [31; 43; 50].
.5
Эпидемиология
Развитие M. graminicola начинается
с перенесения по воздуху аскоспор, в результате чего 1 мІ зараженной пшеницы
может содержать приблизительно 70 различных родов (Рис. 6). Существуют также
некоторые эпидемические особенности связанные с географией распространения,
которые заключаются в том, что в южном полушарии максимальное накоплении
аскоспор наблюдается в период с февраля по апрель, а в северном - август -
октябрь. Дополнительный, вторичный, материал заражения может также быть
доступным в форме пикноспор, который остается жизнеспособным в пикнидах на
остатках после уборки урожая в течение нескольких месяцев. И аскоспоры и
пикнидоспоры способны к заражению растения при условиях высокой влажности, в
результате наличия капельно-жидкой воды [53].
Следует принимать во внимание, что морфологически структуры
полового и бесполого спороношений гриба довольно сходны, по этой причине роль
пикноспор как источника первичной инфекции может быть ошибочно переоценена, а
половая стадия может остаться незамеченной [36].

Рис. 7. Жизненный цикл M. graminicola
[50]
Наконец, потенциальным источником
первичной инфекции могут служить также семена, хотя доказательства этому
отсутствуют. Роль дикорастущих злаков как альтернативных хозяев M. graminicola
в инициировании эпифитотий септориоза остается дискуссионной [25].
Аскоспоры выходят из зрелых псевдотециев в течение года.
Первоначально источниками заражения являются пшеничные обломки и зараженные
растения. Пикнидоспоры могут переноситься к вышерасположенным листьям каплями
дождя, которые переносят материал заражения от обломков или нижних листьев к
вышерасположенным (вертикальный транспорт), или к окружающим листьям
(горизонтальный транспорт). Горизонтальный транспорт возможен также и при отсутствии
дождя, через контакт с окружающими листьями. Но более эффективное
распространение все же с помощью капельно-жидкой воды. Исследования
популяционной генетики M. graminicola определили, что клоны обычно
распространяются в пределах 1 мІ, указывая, что распространения в пределах
посевов ограничены. Показано, что в течение одного вегетационного периода (у
озимой пшеницы), к концу вегетации около 24% изолятов являются продуктами
половой рекомбинации исходных изолятов, заразивших пшеницу в начале вегетационного
периода. Таким образом, аскоспоры служат не только источником первичной
инфекции, но и обеспечивают новые заражения растений в течение одного периода
вегетации [29; 65; 72].
.6
Молекулярные и биохимические аспекты устойчивости
Полной устойчивости (иммунности) пшеницы к Mycosphaerella
graminicola не существует, даже на устойчивых сортах некрозы и / или
пикниды присутствуют всегда. Устойчивость растений проявляется в ограничении
или задержке распространения патогена в тканях хозяина и формирования пикнид.
Относительно механизмов, которые ответственные за ингибирование роста M.
graminicola в устойчивых сортах пшеницы, известно очень мало [50].
Устойчивость пшеницы к M. graminicola является
комплексной, некоторые сорта имеют отдельные доминантные гены устойчивости,
тогда как устойчивость других обусловлена несколькими генами, имеющими
аддитивный эффект. К сожалению, во многих публикациях, в которых анализируются
реакции устойчивости пшеницы к возбудителю септориоза, отсутствует генетический
анализ устойчивости растений. Из-за этого полученные результаты не всегда легко
интерпретировать и обобщать, кроме того имеются также противоречивые сведения.
Тем не менее, к настоящему времени накоплены важные данные, которые вносят
определенную ясность в эту проблему [50].
Прорастание пикноспор и проникновение патогена в подустьичную
полость растения происходили одинаково на восприимчивых и устойчивых сортах
пшеницы [28; 43; 60].
Гистохимическими исследованиями было показано, что
устойчивость пшеницы к септориозу связана с укреплением клеточных стенок
растений, а именно с отложением каллозы. Лигнификации клеточных стенок в случае
взаимодействия устойчивого сорта пшеницы с M. graminicola не
наблюдается [28; 43; 63].
Устойчивость растений не связана с реакцией сверхчувствительности.
Более того, как будет показано ниже, сверхчувствительный отклик пшеницы в
данном случае ассоциирован не с устойчивостью, а с восприимчивостью растений
[39; 43].
Одной из наиболее ранних реакций, связанных с устойчивостью
растений к фитопатогенным организмам, является образование активных форм
кислорода (АФК), наиболее важными из которых являются супероксидный анион,
гидроксильный и гидроксипероксильный радикалы, а также наиболее долгоживущая и
легко обнаружимая перекись водорода (H2O2). АФК могут
оказывать непосредственное антимикробное действие, а также играют ключевую роль
как сигнальные молекулы в координации других реакций устойчивости, включая
реакцию сверхчувствительности. При этом по имеющимся в настоящее время данным,
перекись водорода непосредственно или опосредованно ингибирует рост биотрофных
патогенов, но благоприятствует патологическому процессу, вызываемому
некротрофами [38; 62; 68].
Детальный анализ образования H2O2 при
заражении восприимчивого сорта Sevin и устойчивых сортов Stakado и Flame
показал, что до 11-ти суток после заражения значительно больше перекиси
водорода накапливалось в устойчивых сортах в сравнении с восприимчивым.
Распределение по времени и локализация H2O2 в Stakado
коррелировали с остановкой роста патогена, указывая на роль этой молекулы в
устойчивости. Однако на 13-15 сутки после инокуляции содержание H2O2
значительно возрастало уже в восприимчивом сорте и превосходило ее содержание в
устойчивых сортах, и это совпадало с образованием пикнид и коллапсом клеток
хозяина [44; 45; 60].
Таким образом, перекись водорода в устойчивых сортах пшеницы
накапливается на ранней бессимптомной стадии патологического процесса и тем или
иным способом ингибирует рост и развитие M. graminicola, но при
формировании пикнид и гибели клеток уже восприимчивые растения накапливают ее в
значительных количествах. Происхождение АФК остается невыясненным, но вероятно
в устойчивых сортах на ранней стадии патогенеза их продуцирует растение-хозяин;
накопление же активных форм кислорода на поздней стадии, после гибели клеток
пшеницы, вероятно обусловлено выделением АФК грибом [44; 45].
Роль H2O2 в устойчивости пшеницы к M.
graminicola была подтверждена в экспериментах, в которых в растения
устойчивого и восприимчивого сорта после заражения инфильтрировали перекись
водорода либо каталазу, разрушающую H2O2. Инфильтрация
перекиси водорода делала растения более устойчивыми, тогда как инфильтрация
каталазы и посредством этого удаление H2O2 в значительной
степени снижала устойчивость у устойчивого сорта [61].
У устойчивых сортов пшеницы также показано ранее значительное
увеличение активности пероксидазы. Возможно, этот фермент задействован в
реакциях устойчивости через укрепление клеточных стенок, однако возможно также,
что пероксидаза является одним из источников перекиси водорода, поскольку
пероксидазы клеточной стенки растений являются одним из важных продуцентов
перекиси водорода в реакциях устойчивости растений [38; 60].
При заражении M. graminicola устойчивой линии пшеницы
с геном устойчивости Stb4 и восприимчивой линии, у устойчивой линии была
выявлена экспрессия связанных с патогенезом (Pathogenesis-Related, PR) белков,
а именно PR-1, PR-2 и PR-5. Как известно, PR-белки экспрессируются в устойчивых
растениях после заражения патогенами и предположительно играют роль в защитных
реакциях, хотя функция целого ряда подобных белков неясна. В настоящее время
признается существование 17 классов PR-белков растений, белок PR-1
предположительно обладает антигрибным эффектом и имеет неизвестные свойства,
белок PR-2 является в-1,3-глюканазой, а PR-5 относится к томатин-подобным
белкам [51].
У устойчивой линии пшеницы среди экспрессирующихся генов
также был выявлен ген дисульфидизомеразы, белка, который является хорошо
известным молекулярным шапероном и компонентом путей передачи сигналов у
животных, но не был ранее упомянут как участник реакций устойчивости у растений
[51].
Заслуживает особого упоминания, что экспрессия этих белков
происходила спустя всего три часа после заражения. Таким образом, защитный
отклик пшеницы на заражение M. graminicola начинает разворачиваться
гораздо раньше, чем считали ранее, задолго до проникновения гриба в растения
[51].
Участие PR-2 (в-1,3-глюканазы) в устойчивости растений к
септориозной пятнистости было подтверждено в недавней работе. Накопление
транскриптов соответствующего гена у устойчивого сорта пшеницы Stakado
наблюдалось быстро, уже через 24 часа после заражения. Особенно высокая
активность в-1,3-глюканазы наблюдалась в апопластной жидкости растений пшеницы,
что свидетельствует о локализованном накоплении защитного белка в
непосредственной близости от патогена, который также находится в апопласте. В
противоположность этому, увеличение активности данного белка у восприимчивого
сорта Sevin наблюдалось поздно, только через 9 суток после заражения, перед
некротизацией тканей листьев [63].
Помимо глюканазы, в апопластной жидкости устойчивого сорта
пшеницы накапливались также целый ряд гликопротеинов (типа экстенсина) и
арабиногалактановых белков. Возможно, эти белки наряду с каллозой принимают
участие в укреплении клеточных стенок растений и / или в своего рода
блокировании гиф мицелия фитопатогенного гриба, ограничивая доступность
питательных веществ и распространение патогена в тканях растения [63].
Вклад в устойчивость пшеницы, возможно, вносят внеклеточные
сериновые протеазы, поскольку у восприимчивого сорта заражение приводило к
снижению протеазной активности, тогда как у устойчивого сорта происходило ее
значительное увеличение [54].
Как отмечено выше, защитный отклик пшеницы на заражение M.
graminicola начинает разворачиваться рано, в течение считанных часов после
заражения, до проникновения гриба. Однако полное протекание реакций
устойчивости требует значительно более длительного периода. Детальный анализ
экспрессии генов в устойчивых сортах пшеницы Tadinia (содержит ген устойчивости
Stb4) и W7984 (содержит ген устойчивости Stb8) и не имеющих
известных генов устойчивости к септориозу восприимчивых сортах Yecora Rojo и
Opata 85 выявил, что протекание реакций устойчивости растения охватывает период
до 18-24 суток после заражения. У этих сортов пшеницы были выявлены ранний и
поздний пики экспрессии генов в устойчивых комбинациях. Четыре гена (хитиназы,
фенилаланинаммиаклиазы, белка PR-1 и пероксидазы) начинали экспрессироваться с
высокой интенсивностью на ранней фазе патологического процесса, через 3-24 часа
после заражения, но их экспрессия не обнаруживалась на более поздних этапах. В
то же время девять других генов (АТФазы, 6-оксидазы брассиностероидов,
пептидил-пролилизомеразы, пероксидазы 2, 40S белка рибосом,
АДФ-глюкозопирофосфорилазы, предполагаемого ингибитора протеазы,
метионинсульфоксидредуктазы и белка, подобного предшественнику РНКазы S) имели бимодальный
характер экспрессии с ранним (в пределах 1-3 суток после заражения) и поздним
(12-24 суток после заражения) пиками как минимум в одном из двух устойчивых
сортов. Экспрессия этих генов в восприимчивых сортах происходила на низком
уровне или отсутствовала вообще. Белковые продукты данных генов, как
предполагается, задействованы в реакциях устойчивости в качестве антимикробных
агентов, передатчиков сигналов или регуляторных элементов [22; 51].
Таким образом, несмотря на то, что реакции устойчивости пшеницы
к патогену инициируются очень быстро, спустя считанные часы после заражения, их
полное протекание требует 18-24 суток; к этому времени в восприимчивых сортах
происходит драматические увеличение роста гриба.
.7
Системная приобретенная устойчивость
Индуцированная устойчивость - это природная генотипически
обусловленная устойчивость растений, которая активизируется под влиянием
различных факторов биотической и абиотической природы и определяет определенный
адаптивный потенциал организма. Она представляет собой временную фенотипическую
устойчивость, основанную на экспрессии множества защитных генов, и поэтому
является неспецифической [5].
Индуцированная устойчивость растений к болезням имеет
системный характер. Она проявляется при контакте с патогенами на протяжении
всего или большей части онтогенеза и по своей природе близка к естественным
иммунным реакциям. Выделяют две формы индуцированной устойчивости: системная
приобретенная устойчивость (systemic acquired resistance - SAR) и
индуцированная системная устойчивость (induced systemic resistance - ISR),
которые различаются по характеру возникновения [70].
Индуцированная системная устойчивость индуцируется
стимулирующими рост растений ризобактериями. Имеются также указания, что эти
два типа устойчивости в отношении молекулярных механизмов перекрываются и
одновременно являются антогонистами, но специалисты еще далеки от детального
понимания этих явлений [2].
Системная приобретенная устойчивость представляет собой
механизм индуцированной защиты и развивается в растениях после первичной
инфекции. При этом окружающие ткани или отдаленные части растения становятся
устойчивыми к последующему заражению. Этот тип устойчивости является
неспецифическим; он эффективен по отношению к различным стрессам и повторному заражению
растений, прежде всего к биотическим и абиотическим факторам, которые
индуцируют некрозы клеток и тканей растений. Системная приобретенная
устойчивость развивается либо после индуцированной патогенами реакции
сверхчувствительности, либо после заражения патогенами, индуцирующими некрозы
[34].
Впервые понятие системной приобретенной устойчивости
(systemic acquired resistance - SAR) было введено немецким ученым Россом в 1961
году на основании исследования табака, инфицированного ВТМ. Системная приобретенная
устойчивость развивалась в тканях инфицированного растения, свободных от
заражения. Однако наше понимание биохимических механизмов, связанных с SAR,
мало прогрессировало до открытия PR - белков, коррелирующих с распространением
SAR. Используя систему табак - ВТМ, были обнаружены мРНК по крайней мере 9
семейств генов, которые постоянно индуцируются в незараженных листьях
зараженных растений. Они получили название SAR - генов. Таким образом,
экспрессия SAR - генов коррелирует с состоянием устойчивости [2].
Молекулярно SAR характеризуется повышением экспрессии
большого числа патогенез-зависимых генов (PR генов), и в местных и в системных
тканях. Существует общее мнение, что SAR является результатом согласованных
действий многих PR белков, а не только специфических PR белков. Хотя их роль в
индукции SAR еще не до конца ясна, известно, что PR гены служат полезными
молекулярными маркерами для инициации SAR [34].
Регуляторный
белок NPR1
Ключевой регулятор в развитии SAR является белок NPR1. В
норме NPR1 экспрессируеся в растении в малом количестве, но после проникновения
патогена и обработки SA его уровень повышаетя в два - три раза. Он имеет две
белок-белковые зоны взаимодействия, анкириновые повторности, а также
предполагаемый сигнал ядерной локализации и области фосфорилирования [70].
Когда уровни SA низкие, NPR1 находится в своей олигомерной
форме в цитоплазме, а в ответ на действие SA, регуляторный белок диссоциирует
на мономеры, перемещается в ядро, и взаимодействует с факторами транскрипции
TGA, тем самым, индуцируя экспрессию PR генов [11].
Для активации экспрессии гена PR-1 необходимы факторы
TGA 2, 5 и 6 [59]. Для полной экспрессии данного гена необходим также фактор
транскрипции WRKY70 [21].
Белок NPR1 может регулировать экспрессию гена PR-1
[59].
Ядерная локализация NPR1 и активация TGA факторов возможно
регулируются изменением окислительно-восстановительного потенциала клетки после
обработки SA [73].
Когда белки были исследованы без восстановителя дитиотреитола
(DTT), NPR1 обнаруживался только в обработанных SA образцах, тогда как при
наличии DTT мономеры NPR1 были обнаружены в равных количествах с и без
обработки SA [73].
Было установлено, что роль NPR1 в растениях не ограничивается
SAR. NPR1 играет важную роль при ограничении роста патогенов. NPR1 также
требуется для индуцирования другой защитной устойчивости (ISR), которая
вызывается непатогенными, колонизирующими корни бактериями. NPR1 выступает
посредником между пересекающимися сигнальными путями салициловой кислоты (SA),
жасмоновой кислоты (JA) и этилена (C2H4), которые
вызывают устойчивость к насекомым и некоторым некротрофным патогенам. NPR1
участвует в детоксикации SA и обратной регуляции ее биосинтеза. Кроме того NPR1
участвует в процессах, которые непосредственно не связаны с устойчивостью, например
регуляция клеточного деления [73].
Роль
салициловой кислоты как системной сигнальной молекулы
СК хорошо соответствует требованиям к системным сигнальным
молекулам: она легко распространяется по сосудам флоэмы, поскольку ее
физические свойства близки к идеальным для дистанционного транспорта по
ситовидным трубкам, системно возрастает в десятки раз под влиянием патогенов, и
способна индуцировать у растений некоторые защитные механизмы [70].
В растениях СК присутствует не только в свободной форме, но и
в виде гликозидов, хотя по флоэме транспортируется только свободная форма.
Предполагается, что гликозид - СК является неактивной запасающей формой,
которая может быстро высвобождать СК на участке развивающейся инфекции.
Чрезвычайно интересно, что СК накапливается в растительных тканях только в
ответ на инфицирование, но не возрастает в механически пораженных тканях [2].
О том, что СК является одним из ключевых компонентов в
защитной сигнальной трансдукции, приводящей к индукции SAR - генов,
свидетельствуют данные не только о накоплении СК в растительных тканях при
инфицировании. Более убедительное доказательство было получено в опытах с
трансгенными растениями табака, содержащими бактериальный ген NahG из Pseudamonas
putida, кодирующий гидроксилазу салициловой кислоты - фермент
катализирующий превращение СК в катехол. Экспессирующие этот ген растения не
накапливают СК и неспособны индуцировать SAR на вирусную, бактериальную или
грибную инфекции [8; 28]..
Вплоть до недавнего времени считалось, что биосинтез SA в
растениях осуществляется преимущественно из фенилаланина, посредством фермента
фенилаланинаммиаклиазы (phenylalanine ammonia-lyase или PAL). Высокоспецифичный
ингибитор PAL - аминоиндан-2-фосфорная кислота (aminoindan-2-phosphoric acid
или AIP) подавляла развитие приобретённой устойчивости. Добавление же
экзогенной SA снимало негативный эффект ингибитора и приводило к нормальному
развитию SAR [1].
Недавно было показано, что SA может синтезироваться в
растениях не только из фенилаланина, но и из бензойной кислоты (ВА). При этом
выяснилось, что AIP не влияет на синтез SA из 14С-меченой ВА. Это
позволило предположить наличие у растений PAL-независимого пути синтеза SA [1].
Фермент PAL является светоиндуцируемым. Поэтому в темноте
накопление SA происходит медленно, а защитные реакции протекают с низкой
интенсивностью [1].
Наиболее вероятным местом синтеза СК являются хлоропласты
[8].
На сегодняшний день известно, что в неиндуцированной клетке
салициловая кислота запасается в неактивном состоянии в виде в-гликозида (SA
в-glucoside). Этот гликозид ассоциирован с клеточной стенкой и расщепляется
специфической в-гликозидазой. В ответ на действие стрессоров нетравматического
типа (УФ-излучение, соли тяжелых металлов, колебания температуры, токсины
патогенов) растение отвечает защелачиванием внеклеточного пространства, что
приводит к высвобождению слабо связанных (вероятно ионно-связанных)
в-гликозидаз клеточной стенки, расщеплению гликозида салициловой кислоты и
высвобождению во внеклеточное пространство свободной SA [1].
В 1991 году Чен и Клессинг выделили из тканей табака белок, с
которым связывается СК. Этот белок связывал только СК и ее аналоги, способные
индуцировать устойчивость и экспрессию PR - генов. СК - связывающий белок
оказался каталазой, активность которой блокировалась после связывания с СК.
Отсюда возникло предположение, что в результате блокирования каталазной
активности накапливается перекись водорода, которая либо сама по себе, либо
через другие формы активного кислорода активирует экспрессию защитных генов,
действуя как внутриклеточный мессенджер. Вероятно, ингибирование каталазы
перекрывает основной канал расходной части перекиси водорода, вызывая ее
накопление. Это приводит не только к интоксикации патогенна, но и к СВЧ,
укреплению клеточных стенок в результате сшивок белков и углеводов,
производимых при участии пероксидазы, образованию ингибиторов протеиназ и.т.д.
[2].
Вместе с тем, СК - эндогенный регулятор роста, выполняющий в
растениях разнообразные физиологические функции. Так, СК является естесственным
индуктором термогенезиса в Arum lilies, индуктором цветения
длиннодневных и короткодневных растений семейства рясковых, ингибитором
поступления ионов в корни, ингибитором абсцизовой кислоты в регуляции движения
устьиц. Получены экспериментальные доводы в пользу участия СК в сигнальной
регуляции генной экспрессии в ходе старения листьев арабидопсиса,
предшествующего, как известно, гибели клеток. СК может служить регулятором
транспорта органических веществ по флоэме, гравитропизма и других физиологических
процессов [10].
.8
Контроль заболевания
Самые серьезные потери урожая наблюдаются
при поражении флагового, второго и третьего листьев, ответственных за
обеспечение фотосинтетическими продуктами, которые идут на заполнение зерна.
Контроль нацелен на защиту этих листьев от заболевания и достигается с помощью
использования устойчивых сортов или фунгицидов [27; 30].
Мало известно о генах которые поддерживают
устойчивость, и сорта, которые устойчивы в одной части мира, могут быть
чувствительны в другой, что объясняется отличиями в генотипе патогенов и
окружающих условиях. Полной устойчивости к M. graminicola не существует,
таким образом некрозы и / или пикниды всегда присутствуют, и любое ограничение
или задержка патогенного развития расценены как форма устойчивости. Культурные
сорта растения с хорошей устойчивостью М. graminicola существуют, но их
урожай значительно меньше, чем у восприимчивых культурных сортов растения
обработанных фунгицидами. Следовательно, контроль состоит в разработке
противогрибных препаратов [46; 50].
За прошедшие 15 лет было рекомендовано
множество препаратов по контролю за М. graminicola. Они включают
множество 14 - деметилазных ингибиторов биосинтеза стирола (ципроконазол и
епоксиконазол) и некоторые широкого спектра, системные фунгициды
(азоксистробин). Системные фунгициды останавливают митохондриальное дыхание,
блокируя электронную передачу между цитохромом b и цитохромом c [46; 48; 50].
Предложенные фунгициды обычно эффективны
при соответствующих погодных условиях, так как выход спор непосредственно
коррелируется доступностью свободной воды. Если погодные условия предусмотрены,
тогда распространение инфекции может блокироваться фунгицидом.
С появлением методов предсказывания и
диагностики заболевания использование фунгицидов экономически выгодно [27; 30].
.9
Требования по охране труда
Охрана труда - это система правовых, социально-экономических,
организационно-технических, санитарно-гигиенических и лечебно-
профилактических мероприятий и средств, направленных на
сохранение жизни, здоровья и трудоспособности человека в процессе трудовой
деятельности [20].
Безопасность работ в лабораториях микробиологического профиля
(далее лаборатории) должна обеспечиваться согласно требованиям ГОСТ 12.3.00275,
12.1.008-76 [19].
Требования данных правил обязательны для исполнения всеми
организациями / учреждениями (лабораториями) на территории Украины, независимо
от ведомственной принадлежности и форм собственности, которые проводят работу
[6].
. Общие положения:
.1. Помещение лаборатории должно быть оборудовано
противопожарным инвентарем, приточно-вытяжной вентиляцией, иметь водопровод,
канализацию, подводку газа и электроэнергии, центральное отопление и горячее
водоснабжение [6].
.2. Все учебные комнаты и другие помещения, где проводится
работа с микробиологическим материалом, должны быть оборудованы бактерицидными
лампами [6].
.3. Для работы в лаборатории допускаются лица, прошедшие
ознакомление с инструкциями по охране труда при работе в лаборатории и оказанию
первой помощи. В каждой лаборатории должны быть составлены собственные «Правила
техники безопасности», учитывающие специфические условия работы, характерные
для данной лаборатории [6].
.4. Перед началом работы необходимо переодеться в специальную
одежду (халат, шапочка / косынка, перчатки, маска), сменную обувь, легко
обрабатываемую дезинфицирующим раствором. Специальная одежда, обувь и другие
средства индивидуальной защиты должны соответствовать характеру и условиям
работы, обеспечивать безопасность труда, подбираться индивидуально для каждого
работника, закрепляться за ним и храниться отдельно от личной одежды [6; 21].
.5. Перед началом работы предметы на столе необходимо
разместить так, чтобы середина стола была свободной. Дезинфицирующие растворы
для обработки рук, емкость для пипеток, банка для отходов должны находиться
справа от работника на расстоянии, что позволяет, не вставая с рабочего места,
обрабатывать руки, погружать в дезинфицирующий раствор пипетки и другой
отработанный материал. Газовая горелка или спиртовка должны находиться в центре
стола, на расстоянии 30 см от его края со стороны работающего. Объекты с
посевами, незасеянные питательные среды располагают слева на одном уровне с
горелкой. Культуру с поверхности агара собирают петлей, металлическим,
стеклянным или пластиковым шпателем [6].
.6. На посуде с материалом, который исследуется, должны быть
надписи: наименование материала или культуры (по бинарной номенклатуре), дата
посева [6].
.7. Готовые питательные среды хранят на расстоянии от
приборов отопления, защищенными от воздействия прямых солнечных лучей.
.8. Токсичные реактивы подлежат обязательному учету и
хранению в специально выделенных для этого сейфах, металлических шкафах
(ящиках) под замком [6].
.9. Всю работу с концентрированными кислотами и щелочами
проводят в вытяжном шкафу, пользуясь при этом очками, резиновыми перчатками и
фартуком; концентрированную кислоту отбирают из сосуда только с помощью
специальной пипетки с грушей или сифоном. Слив отработанной кислоты или щелочи
в канализацию допускается только после предварительной нейтрализации [6].
.10. Перенесение материала из одной емкости в другую
(независимо биологический материал или вещество) осуществляется с помощью
груши, дозатора и т.д. Пипетирование ртом строго запрещено [6].
.11. При работе со стеклянными приборами необходимо: защищать
руки полотенцем при сборе стеклянных приборов или соединении отдельных частей;
собирают стеклянные приборы и детали в местах, оборудованных подкладками
(пиноуретан, резина и др.). При возможности стеклянную посуду и стеклянные
части заменяют пластиковыми [6].
.12. Все зараженные материалы, образцы и культуры должны быть
обезврежены перед удалением из лаборатории.
.3. Формирование емкостей для обеззараживания производится
непосредственно в учебных комнатах. Обеззараживание материала осуществляется с
помощью автоклавирования, с обязательным контролем в соответствии с МВ №15/6-5
от 28.02.91.
.14. По окончании рабочего дня каждый работник лаборатории
обязан проверить и привести в порядок свое рабочее место, приборы и аппараты,
отключить вентиляцию, проверить закрытие кранов газовых горелок, всех
электронагревательных приборов, закрытие водяных кранов, окон. Отключить
освещение [19].
Добросовестное выполнение обязанностей по охране труда
уменьшает риск возникновения ситуаций, создающих угрозу жизни и здоровью [19].
2. Объекты и методы
Объектами выступали озимая пшеница сорта Виктория, сорт Астет
и гриб М. graminicola.
.1
Выделение патогена в чистую культуру
Выделение гриба производили в стерильных условиях. Пораженные
кусочки листиков пшеницы размером 0,5Ч0,5 см промывали проточной водой, а затем
в несколькими порциями стерильной воды и закладывали во влажную камеру на 3-6
часов в стерильную чашку. Затем под бинокуляром с помощью иглы кусочки цирей
распределяли штрихом по чашке Петри со средами Чапека и КГА. Гриб
культивировали при температуре 18-25° С. Сохраняли гриб на косячках в пробирках
на КГА в течении 10-12 месяцев без пересева.
.2
Наблюдение за ростом колонии
С помощью иглы переносили инокулюм из пробирки в центр чашки
Петри со средами Чапека и КГА. Через каждых три дня производили наблюдения за
ростом и морфологией колони.
.3
Наработка споровой массы для инокуляции растений
Материал для заражения получали двумя методами:
. Культивированием М. graminicola на зернах пшеницы,
овса и на перловой крупе;
. Выращиванием гриба в чашках Петри на КГА.
Для первого метода использовались колбы на 50 мл. В каждую из
колб помещалось по 7 г зерен пшеницы, овса и перловой крупы соответственно,
добавляли по 7 мл дистиллированной воды. Колбы закрывали пробками и
стерилизовали. Далее в колбы со стерильным содержимым помещали по 7 мл
суспензии пикноспор с частичками мицелия (материал предварительно наращивался
чашках Петри на КГА, сеяли штрихами). В течении 10 дней происходило наращивание
мицелия и к 9-ому - 10-ому дню образовываются пикниды. Для равномерного
нарастания мицелия, колбы ежедневно встряхивали. Суспензирование спор
производили в расчете 1 г материала на 10 мл воды (встряхивали).
Для второго метода на первом этапе патоген выращивали на
косячках в течении 14 дней, затем наливали в каждый косячок по 2 мл стерильной
воды, выдерживали 15-20 мин, встряхивали и выливали полученную суспензию
пикноспор на чашки Петри, равномерно распределяя. Далее наращивание материала
производили в течение 7 дней при рассеянном свете при температуре 18-25оС.
Суспензирование производили путем залива колоний в Чашке Петри 10 мл воды
(скоблили) [23; 25].
.4
Заражение пшеницы
Анализ проявления септориоза на листьях проростков пшеницы
проводили методом, описанным Arrainol с соавторами [23].
Для заражения использовали проростки озимой пшеницы в
возрасте от 11 до 20 дней. Пшеницу проращивали в пластиковых горшочках
диаметром 6,5 см, помещая в каждый по 7 зерен. Проращивание осуществлялось при
комнатной температуре, 16-и часовом освещении и его мощности 10000 люкс [23].
Проростки пшеницы равномерно опрыскивали суспензией пикноспор
с концентрацией 1Ч108 спор/мл из расчета 50 мл суспензии на 7
растений пшеницы. Растения оставляли на 30 мин. для подсыхания, затем делали
отрезок 3,5 см из центральной части первых листьев. Предварительно готовили
водный агар, содержащий 100 мг л-1 бензимидазола (для задержки
старения). Водный агар с бензимидазолом по 50 мл распределяли в нестерильные
чистые пластиковые ящички (8Ч12Ч2 см). В центре агара вырезали прямоугольные
сегменты. Отрезки листьев проростков укладывали вверх верхней поверхностью
поперек промежутков, так что срезанные концы оставались на агаре. Промежутки
под листьями помогали предотвращать пропитку водой и загрязнение другими
микроорганизмами. В каждый ящичек помещалось от восьми до десяти отрезков
листьев. Полоски агара затем помещали поверх срезанных концов отрезков листьев,
так что они не были выставлены на воздух, таким образом, задерживая старение.
Ящички далее закрывали и накрывали черным пластиком (или фольгой) для
сохранения их в темноте. После инкубации при 20 оС в течение 48
часов ящички разворачивали и оставляли при рассеянном свете на 14 дней.
Определение поражения (наблюдение формирования пикнид) осуществлялось с помощью
бинокуляра [23].
Поражения отрезков листиков оценивали с помощью шкалы в
процентах. Данная шкала рассматривала отношение площади покрытой пикнидами к
отрезку листа. Для определения относительной площади отрезков листиков и
площади покрытой пикнидами использовали Adobe Photoshop CS3 [9].
.5
Индукция системной приобретенной устойчивости у растений
Для осуществления данной процедуры использовали проростки
растений пшеницы в возрасте от 11 до 14 дней. Растения выращивали как в п/п
2.3. и обрабатывали раствором салициловой кислоты (концентрация 1мМ). Обработку
производили ручным опрыскивателем. Контрольные растения опрыскивали
дистиллированной водой. На 20-ый день выполняли заражение проростков пшеницы
вышеуказанным методом (п/п 2.3). Поражения оценивали на седьмые, десятые и
пятнадцатые сутки методом описанным в п/п 2.3. Для определения относительной
площади отрезков листиков и площади покрытой пикнидами использовали Adobe
Photoshop CS3 [8; 71].
2.6
Статистическая обработка данных
Садистическая обработка данных проводилась с использованием
дисперсионного анализа и критерия Стьюдента. Вычисления проводились при помощи
программы Statistica 6.0.
3. Результаты собственных исследований
.1
Рост в чистых культурах
Все колонии М. graminicola характеризовались
медленным ростом. В начальный период формирования они имеют вид бактериальной
колонии телесного цвета с более темной серединой. Место, куда вносят инокулюм,
как правило, было немного выше.
На КГА размер колоний был наибольшим,
мицелиального типа, темно-серого цвета с гофрированной (складчатой)
поверхностью (Рис. 6). Их размер в период от 10-х до 20-х суток увеличивается
приблизительно в 4 раза. В дальнейшем (до 30-и суток) рост колоний значительно
замедлялся. Максимальный диаметр колонии составляет около 36,7 мм. Через 20 -
25 суток наблюдалось растрескивание среды на сегменты с нижней стороны чашки
Петри.
Рис. 7. Развитие Septoria tritici на КГА
На среде Чапека изоляты гриба обычно формируют компактные слизистые
колонии бактериального типа (Рис. 7). Иногда наблюдается очень редкий мицелий,
который застилает поверхность среды. Пигментация колонии находится в
розово-желтых тонах. На этой питательной среде обычно все изоляты развиваются
очень медленно - размер колоний наименьший и составляет от 9, 1 до 20,8 мм. На
среде Чапека не отмечено формирования пикнид.
Рис. 9. Развитие Septoria tritici на среде Чапека
На КГА на 15-20 сутки культивирования гриба отмечено формирование
пикнид. При развитии большого количества пикнид колония приобретает
гранулированный вид. Также характерно появление белого стерильного мицелия
через 20-25 суток, что свидетельствует о начале переростания культуры.
Вследствие этого гриб теряет способность к спороношению.
Следует отметить также, что по мере увеличения количества
пересевов в последующих генерациях наблюдается задержка роста колоний. Колонии
изолятов наиболее интенсивно развивались при температуре 20 - 25 оС.
Полученные результаты М. graminicola соответствуют
литературным данным [6; 10].
.2
Наработка споровой массы для инокуляции растений
При использовании первого метода наибольшее спороношение
выявлено на перловой крупе (106 спор/мл), на остальных же
субстратах, несмотря на активное развитие гриба, образование спор было
одинаково невысоко (пшеница -104спор/мл, овес - 103спор/мл).
Второй метод оказался более эффективным и удобным (Рис. 10).
При выращивании культур на Чашках Петри с шестого по седьмой день была получена
концентрации спор - 108 спор/мл.

Рис. 10. Наработка споровой массы на различных субстратах
.3
Заражение пшеницы
После заражения пшеницы на 7-ые сутки наблюдались
хлоротические пятна на опытных отрезках листиков пшеницы (Рис. 11). Визуальных
различий в проявлении заболевания между сортами на данном этапе не наблюдалось.
Даже на 10-ые сутки после заражение сортовые различия в устойчивости нельзя
было выявить подобным методом. Далее хлороз распространялся по всему участку
листика (Рис. 12). Контрольные варианты листиков оставались незараженными и без
существенных изменений.

Рис. 11. Результаты опыта по заражению на 7-ые сутки: К -
контроль; О - опыт (отрезки зараженных растений)

Рис. 12. Результаты опыта по заражению на 10-ые сутки
(наблюдается увеличение площади хлороза): К - контроль; О - опыт (отрезки
зараженных растений)
Об успешности проведения заражения свидетельствовало наличие
пикнид, которые начали появляться на пятнадцатые сутки (Рис. 13). В качестве
показателя устойчивости использовали долю поверхности листьев занятой
пикнидами.
Средняя величина поражения у сорта Астет 15%, а сорта
Виктория - 6,3%. Разница между сортами по результатам расчета критерия
Стьюдента оказалась высокозначимой (р< 0,001).
Таким образом, использованный метод учета заражения позволил
оценить разницу в устойчивости к септориозу сортов Виктория и Астет (6,3% и 15%
соответственно).

Рис. 13. Результаты опыта по заражению на 15-ые сутки
(образование пикнид).
.4
Индукция системной приобретенной устойчивости у растений
На заключительном этапе мы попытались индуцировать системную
приобретенную устойчивость. Используя методики заражения и индукции системной
приобретенной устойчивости пшеницы, удалось получить положительные результаты.
Начиная с первых этапов, на седьмые сутки, уже была отмечена разница в
проявлении устойчивости. Отрезки листьев растений пшеницы, обработанные
раствором салициловой кислоты (опытные образцы), были более зеленые и свежие в
сравнении с контрольными образцами как с сортом Виктория, так и сортом Астет
(Рис. 14). В растениях с индуцированной устойчивостью наблюдалось появление
пятен розовой окраски, что вероятно свидетельствует о накоплении антоцианов у
обоих сортов. В контроле наблюдались типичные проявления септориоза на седьмые
сутки.


Рис. 14. Индукция системной приобретенной устойчивости
пшеницы на 7-ые сутки: А. сорта Виктория; Б. Сорта Астет; О - отрезки растений,
обработанных раствором салициловой кислоты; К - контроль
В дальнейшем в опытных образцах увеличивались в основном
антоциановые пятна, тогда как в контрольных - возрастала только площадь хлороза
(Рис. 15).
На 15-ые сутки было отмечено формирование пикнид, как в
опытных так и контрольных образцах (Рис. 16). Однако пораженность растений
значительно снизилась и составила в среднем 2,7% у сорта Виктория, тогда как в
контрольных - 6,3%, Астет - 8%, а контроль - 15%. В опытных образцах
наблюдались области нехлоротизированной ткани и накопление антоцианов в обоих
сортах.


Рис. 15. Индукция системной приобретенной устойчивости
пшеницы на 10-ые сутки: А. сорта Виктория; Б. сорт Астет; О - отрезки растений,
обработанных раствором салициловой кислоты; К - контроль
Результаты дисперсионного анализа выявили значительные
различия между контролем и опытом, а также между сортами (Рис. 17).
Таблица 1
|
Результаты
дисперсионного анализа
|
SS
|
df
|
MS
|
F
|
p
|
|
Сорт
|
110,776
|
1
|
110,776
|
1559,30
|
0,000000
|
|
Обработка
|
172,266
|
1
|
172,266
|
2424,85
|
0,000000
|
|
Сорт Ч
обработка
|
13,141
|
1
|
13,141
|
184,97
|
0,000000
|
|
Ошибка
|
0,852
|
12
|
0,071
|
|
|


Рис. 16. Индукция системной приобретенной устойчивости
пшеницы на 15-ые сутки: А. сорта Виктория; Б. сорт Астет; О - отрезки растений,
обработанных раствором салициловой кислоты; К - контроль

Рис. 17. Общие результаты индукция системной приобретенной
устойчивости пшеницы
Таким образом, результаты нашей работы показали, что у
растений пшеницы благодаря индукции системной устойчивости снижение
пораженности составило от 56% до 61%. Заслуживает также упоминание, что
индукция системной защитной реакции связана с накоплением антоцианов. Ранее
подобной защитной реакции в данной патосистеме показано не было.
Выводы
1. При росте на КГА M. graminicola
формирует строматично - мицелиальный тип колоний, на Чапека - дрожжевой.
Колонии M. graminicoia на обеих средах характеризуются медленным ростом.
На пятнадцатые - двадцатые сутки на КГА наблюдается формирование пикнид.
. Наращивание споровой массы в чашках
Петри для заражения растений наиболее удобный и менее продолжительный метод по
сравнению с наработкой на зернах злаков.
. Используемые сорта пшеницы различались
по устойчивости к септориозу. Площадь поверхности покрытая пикнидами составила
у сорта Виктория 6,3%, у местной линии - 15%.
. Была индуцирована системная
приобретенная устойчивость у пшеницы к M. graminicola путем ее обработки
салициловой кислотой. Пораженность обоих сортов снизилась на 56 - 61%.
Список литературы
септориозный пшеница устойчивость системный
Режим
доступа: http://www-biology.univer.kharkov.ua/micology/doslid_ak.htm
2.
Дьяков Ю.Т. Общая и молекулярная фитопатология / Ю.Т. Дьяков, О.Л.
Озерецковская, В.Г. Джавахия, С.Ф. Багирова // Учебное пособие. - М.: Изд - во
Общество фитопатологов, 2001. - 211-300.
3.
Манько О.П. Влияние условий культивирования на развитие септориоза пшеницы Septoria
tritici Rob. еt Desm./ О.П. Манько, В.И. Глущенко // Биологический вестник.
-1997. - Т.1, №2. - С. 100-105.
.
Мюллер Э. Микология / Э. Мюллер, В. Лёффлер. - М.: Мир., 1995 - 343 с.
.
Поликсенова В.Д. Индуцированная устойчивость растений к патогенам и
абиотическим стрессовым факторам // Вестник БГУ. - 2009. - сер. 2, N.1. - 48-58
с.
6.
Правила устройства и безопасности работы в лабораториях микробиологического
профиля: государственные санитарные правила: ДСП 9.9.5. - 080-02].
7.
Тетеревникова-Бабаян Д.Н. Грибы рода Септория в СССР. - Ереван, Изд-во АН
АрмССР. - 1987. - 479 с.
.
Трошина Н.Б. Индукция салициловой кислотой устойчивости пшеницы к Septoria
nodorum Berk./Н.Б. Трошина, Л.Г. Яруллина, А.Ш. Валеева // Известия РАН.
Серия биологическая. - 2007. - №5. - С. 545-550.
.
Санина А.А. Septoria tritici Rob. etDesm. - возбудитель пятнистости листьев
пшеницы/А.А. Санина, Л.В. Анциферова, Л.В. Супрун // Микология и фитопатология.
- 1980.-Т.20, №4. - С. 300-306.
.
Шакирова Ф.М. Неспецифическая устойчивость растений к стрессовым факторам и ее
регуляция / Ф.М. Шакирова. - УФА: ГИЛЕМ, 2001. -130 с.
11.
Шамрай С.Н. Гены устойчивости растений: молекулярная и генетическая
организация, функция и эволюция/С.Н. Шамрай // Журн. общ. биол. - 2003. - Т.64,
№3. - С. 195-214.
.
Бушулян М.А. Вихідний матеріал для селекції озимої пшениці щодо стійкості до
збудника септоріозу (Septoria tritici Roberge in Desmaz.) в умовах
півдня України: автореф. дис. на здобуття наук. ступеня канд. сільскогосп.
наук: спец. 06.01.06 «Селекція рослин»/ М.А. Бушулян. - Одеса, 2003. - 16 с.
13.
Гриби України (інтерактивна база даних). - режим доступу до сайту:
[http://www.cybertruffle.org.uk/robigalia/rus].
.
Дерменко О.П. Збудник септоріозу озимого тритикале / О.П. Дерменко // Наукові
доповіді НАУ. - 2008. - №9. - С. 1-7.
.
Коваленко С.М. Культуральні та морфологічні особливості Septoria tritici Desm./С.М.
Коваленко // Укр. бот. журн. - 1977. - Т.34, №1. - С. 51-54.
.
Лисенко С.В. Септоріоз листя: вплив мікроклімату травостою на розвиток хвороби
в посівах озимої пшениці/С.В. Лисенко, С.І. Коломієць // Захист рослин. - 1998.
- №4. - С. 8.
.
Марютін Ф.М. Септоріозна плямистість листя/Ф.М. Марютін, Зіад Баракат Равашдех
// Захист рослин. - 2002. - №8. - С. 4-5.
.
Морочковський С.Ф. Визначник грибів України: у 5т. / С.Ф. Морочковський, М.Я.
Зерова, З.Г. Лавітська, М.Ф. Смицька. - К.: Наукова Думка, 1969 - - ТІІ:
Аскоміцети. - 569 c.
.
Про державний санітарно-гігієнічний нагляд в Україні: Положення від 22 червня
1999 р. №1109 // Офіційний вісник України. - 1999. - №25. - С. 127
.
Про охорону праці: Закон України від 14 жовтня 1992 р. №2695 - ХІІ // Офіційний
вісник України. - 1997. - №13. - С. 145.
.
Про порядок забезпечення робітників спеціальним одягом, взуттям та іншими
засобами індивідуального захисту: Наказ від 21 травня 2008 р. №53 // Офіційний
вісник України. - 2008. - №38. - С. 98.
22. Adhikaria T.B. Resistance of wheat to Mycosphaerella
graminicola involves early and late peaks of gene expression/ Т.В. Adhikaria, В. Balajib, J. Breedena //
Physiol. Molec. Plant Pathol. - 2007.-V.71, №1-3.-P. 55-68.
. Arrainol L.S. A detached seedling leaf techniques to study
resistance to Mycosphaerella graminicola in wheat/ L.S. Arrainol, P.A.
Brading, J.K.M. Brown // Plant Pathology. - 2001. - V.50, №3. - P. 339-346.
. Brokenshire T. Wheat debris as an inoculum source for seedling
infection by Septoriatritici/Т. Brokenshire // Plant Pathology.-1975a. - V. 24.
- P. 202-207.
. Brokenshire T. Wheat seed infection by Septoria tritici/Т. Brokenshire //
Transactions of the British Mycological Society.-1975b. - V.64. - P. 331-334.
26. Brown J.S. Distribution and dissemination of Mycosphaerellagraminicola
(Fuckel) Schroeter in relation to the epidemiology of speckled leaf blotch of
wheat/ J.S. Brown, A.W. Kellock, R.G. Paddick //Australian Journal of
Agricultural Research. - 1978. - V.29, №6. - P. 1139-1145.
27. Chungu C. Septoria tritici blotch development as affected by
temperature, duration of leaf wetness, inoculum concentration, and host/С. Chungu, J. Gilbert, F.
Townley-Smith // Plant Dis. - 2001. - V.85, №4. - P. 430-435.
. Cohen L. The histology of processes associated with the
infection of resistant and susceptible wheat cultivars with Septoriatritici/
L. Cohen, Z. Eyal //Plant Pathology. - 1993. - V.42. - Р. 737-743.
. Cordo C.A. Morphocultural variants of Septoria tritici
isolates/С.А. Cordo, А.Е. Perellу, Н.Е. Alippi // Rev
IberoamMicol., - 1997.-V.14.-Р. 168-172.
. Cordo C.A. Spore dispersal of leaf blotch pathogens of wheat (Mycosphaerellagraminicolaand
Septoriatritici)/ С.А. Cordo, А.Е. Perellу, M.R. Simуn // Proceedings of the
International Septoria Workshop, Mexico, DF (Mexico), 20-24 Sep 1999.-CIMMYT,
1999. - P. 98-101.
31. Cowder C. Specific adaptation by Mycosphaerella graminicola
to a resistant wheat cultivar/ С. Cowder, М.Е. Hoffer, С.С. Mudt //
Plant Pathology. - 2000. - V.49. - P. 445-451.
. Dickinson M. Molecular plant pathology/М. Dickinson. - London,
New York: BIOS Scientific Publishers, 2003. - 273 p.
. Duncan K.E. Cytologycal analisis of wheat infection by the leaf
blotch pathogen Mycosphaerella graminicola/К.Е. Duncan, R.J. Haward/К.Е. Duncan // Mycol. Res. -
2000. - V.104, №9. - P. 1074-1082.
. Durrant W.E. Systemic asquired resistance / W.E. Durrant, X.
Dong // Annu. Rev. Phytopathology. - 2004. - Vol. 42. - P. 185-209.
. Eyal Z. The Septoria tritici and Stagonospora
nodorum blotch diseases of wheat / Z. Eyal // Eur. J. Plant Pathol. - 1999.
- V.105, №7. - Р. 629-641.
. Eyal Z. The Septoria diseases of wheat: Concepts and methods of
disease management/ Z. Eyal, A.L. Scharen, J.M. Prescott - Mexico, D.F.:
CIMMYT. - 1987. - 52 р.
37. Halama P. The occurrence of Mycosphaerellagraminicola,
teleomorph of Septoriatritici in France/Р. Halama // Plant Pathology. - 1996. -
V.45, №1. - P. 135 - 138.
38. Hammond-Kosack K.E. Resistance gene-dependent plant defense
responses/К.Е. Hammond-Kosack, J.D.G.
Jones // Plant Cell. - 1996.-V. 8, №10. - Р. 1773-1791.
39. Hammond-Kosack K.E. Plant resistance signalling hijacked by a
necrotrophic fungal pathogen/К.Е. Hammond-Kosack, J.J. Rudd // Plant Signaling & Behavior. -
2008.-V.3, №11. - Р. 993-995.
. Harrower K.M. Studies on spore forms of Septoria tritici
from New South Wales/ K.M. Harrower // Australian Plant Pathology Society
Newsletter. - 1976. - V.5, №3.-P.33
. He P. Elicitation and suppression of microbe-associated
molecular pattern-triggered immunity in plant-microbe interactions/Р. Не, L. Shan, J.
Sheen // Cell. Microbiol. - 2007. - V.9, №6. - P. 1385-1396.
. Hess D.E. Efect of moisture and temperature on development of Septoria
tritici blotch in wheat / D.E. Hess, G. Shaner // Phytopathology. - 1987. -
V.77, №2. - P.215-219.
. Kema H.J. Histology of the Pathogenesis of Mycosphaerella
graminicola in Wheat/ H.J. Kema, Y. DaZhau // Phytopathology. - 1996. -
V.86, №7. - P.777-786.
. Keon J. Metabolic and stress adaptation by Mycosphaerella
graminicola during sporulation in its host revealed through microarray
transcription profiling/ J. Keon, J.J. Rudd, J. Antoniw // Mol. Plant Pathol. -
2005.-V.6, №5. - P. 527-540.
. Keon J. Transcriptional adaptation of Mycosphaerella
graminicola to programmed cell death (PCD) of its susceptible wheat host/
J. Keon, J. Antoniw, R. Carzaniga // Mol. Plant Microbe Interact. - 2007.-V.20,
№2. - P. 178-193
. Knight S.C. Rationale and perspectives on the development of
fungicides/ S.C. Knight, V.M. Anthony, A.M. Brady // Annu. Rev. Phytopathol. -
1997. - V.35. - P. 349-372.
. Lovell D.J. Effect of temperature on latent period of septoria
leaf blotch on winter wheat under outdoor conditions / D.J. Lovell, Т. Hunter, S.J. Powers //
Plant Pathol. - 2004.-V.53, №2. - P. 170-181.
. Mavroeidi V.I. Sensitivity distributions and cross-resistance
patterns of Mycosphaerella graminicola to fluquinconazole, prochloraz
and azoxystrobin over a period of 9 years / V.I. Mavroeidi, M.W. Shaw // Crop
Protection. - 2005.-V.24, №3.-P. 259-266.
.
Mycobank (інтерактивна база даних). - режим доступу до сайту:
(http://www.mycobank.org/)
50. Palmer C.L. Mycosphaerella graminicola: latent
infection, crop devastation and genomics / C.L. Palmer, L.P. Skinner //
Molecular Plant Pathology. - 2002. - V.3, №2. - P. 63-70.
. Ray S. Rapid induction of a protein disulfide isomerase and
defense-related genes in wheat in response to the hemibiotrophic fungal
pathogen Mycosphaerella graminicola / S. Ray, J.M. Anderson, F.I. Urmeev
// Plant Mol. Biol.
- 2003. - V.53, №5. - P. 741-754.
52. Sanderson F.R. A Mycosphaerella species as the
ascogenus state of Septoria tritici Rob. exDesm./ F.R. Sanderson // New
Zealand Journal of Botany. - 1972. - V.10. - P.707-709.
53. Scharen A.L. Biology of the Septoria/Stagonospora
pathogens: an overview/ A.L. Scharen // Proceedings of the International
Septoria Workshop, Mexico, DF (Mexico), 20-24 Sep 1999. - CIMMYT, 1999. - P.
19-22.
. Seggarra C.I. Changes in wheat leaf extracellular proteolytic
activity after infection with septoria tritici / C.I. Seggarra, C.A.
Casalonguй, M.L. Pinedo
// J. Phytopath. - 2002. - V.150, №3. - P. 105-111.
. Shaw M.W. Effects of temperature, leaf wetness and cultivar on
the latent period of Mycosphaerella graminicola on winter wheat / M.W.
Shaw // Plant Pathol. - 1990. - V.39, №. - P. 255-268.
. Shaw M.W. Interacting effects of interrupted humid periods and
light on infection of wheat leaves by Mycosphaerella graminicola (Septoria
tritici) / M.W. Shaw // Plant Pathol. -1991. - V.40, №4. - P. 595-607.
. Shaw M.W. Epidemiology of Mycosphaerella graminicola and Phaeosphaeria
nodorum: an overview / M.W. Shaw // Proceedings of the International
Septoria Workshop, Mexico, DF (Mexico), 20-24 Sep 1999. - CIMMYT, 1999. - P.
93-97.
. Shaw M.W. Airborne inoculum as a major source of Septoria
tritici (Mycosphaerella graminicola) infections in winter wheat
crops in the UK / M.W. Shaw, D.J. Royle // Plant Pathol. - 1989. - V.38, №1. -
P.35-43.
. Shaw M.W. Factors determining the severity of epidemics of Mycosphaerella
graminicola (Septoria tritici) on winter wheat in the UK/ M.W. Shaw,
D.J. Royle // Plant Pathol. - 1993. - V.42, №5. - P.882-899.
. Shetty N.P. Association of hydrogen peroxide with restriction of
Septoria tritici in resistant wheat / N.P. Shetty, B.K. Kristensen, P.L.
Gregersen // Physiological and Molecular Plant Pathology. - 2003. - V.62. - P.
333-346.
. Shetty N.P. Role of hydrogen peroxide during the interaction
between the hemibiotrophic fungal pathogen Septoria tritici and wheat/
N.P. Shetty, R. Mehrabi, Н. Lьtken // New Phytol. - 2007. - V.174, №3. - P. 637-647.
. Shetty N.P. Roles of reactive oxygen species in interactions
between plants and pathogens / N.P. Shetty, H.J.L. Jшrgensen, J.D. Jensen //
Eur. J. Plant Pathol. - 2008. - V.121, №3. - P.267-280.
. Shetty N.P. Effects of в-1,3-glucan from Septoria tritici on
structural defence responses in wheat / N.P. Shetty, J.D. Jensen, А. Knudsen // J. Exp. Bot.
- 2009.-V.60, №15. - P. 4287-4300.
. Shipton W.A. The common Septoria diseases of wheat / W.A.
Shipton, W.R.J. Boyd, А.А. Rosielle //
Bot. Rev. - 1971. - V.37, №. 2 - P.231-262.
. Torriani S.F.F. QoI resistance emerged independently at least 4
times in European populations of Mycosphaerella graminicola/ S.F.F.
Torriani, P.C. Brunner, B.A. McDonald // Pest Management Science. - 2009.-V.65,
№2. - P. 113 - 227.
. Wainshilbaum S.J. Effect of temperature and growth stage of
wheat on development of leaf and glume blotch causes by Septoria tritici and
S. nodorum/ S.J. Wainshilbaum, P.E. Lipps // Plant Dis. - 1991.-V.75,
№10.-P. 993-998.
. Weber G.F. Septoria diseases of Wheat/ G.F. Weber //
Phytopathology. - 1922. - V.12. - P. 537-588.
. Van Kan J.A.L. Licensed to kill: the lifestyle of a necrotrophic
plant pathogen/ J.A.L. Van Kan // Trends Plant Sci. - 2006.-V.11, №5. - Р. 247-253.
. Viljanen-Rollinson S.L.H. Latent periods of septoria tritici
blotch on ten cultivars of wheat/ S.L.H. Viljanen-Rollinson, M.V. Marroni, R.C.
Butler // N.Z. Plant Prot. - 2005.-V.58.-P. 256-260.
70. Vallad G.E. Systemic acquired resistance / G.E. Vallad, R.M.
Goodman // Crop Science Society of America. - 2004. - Vol. 30. - N. 3. - P.
325-328.
. Zhang Y. Interaction of NPR1 with basic leucine zipper protein
transcription factors that bind sequences required for salicylic acid induction
of the PR-1 gene / Y. Zhang, W. Fan, M. Kinkema [et al.] // Plant Biology. -
1999. - Vol. 96. - P. 6523-6528.
. Zwiers L.H. ABC transporters and azole susceptibility in
laboratory strains of the wheat pathogen Mycosphaerella graminicola/
L.H. Zwiers, І.
Stergiopoulos, J.G. Van Nistelrooy // Antimicrobial Agents and Chemotherapy. -
2002.-V.46, №12.-P. 3900-3906.